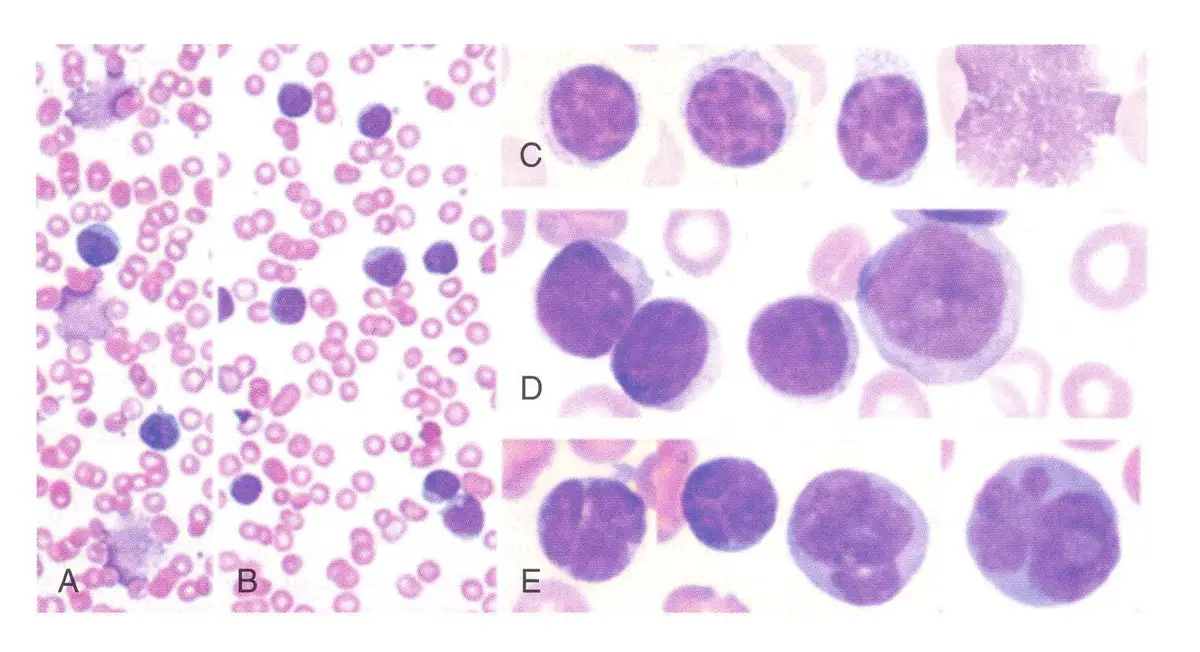
圖片

106年:(醫檢)血液(2)
承上題【承上題【一位 75 歲的男性病患, CBC 檢查結果 Hb=13.5 g/dL 、WBC=150,000/ µL、platelet=80,000/ µL;血液抹片如下圖,則此血液抹片可觀察到那些異常現象? ①lymphocytosis ②increased smudge cells ③prolymphocytes ④Reed-Sternberg cells⑤Faggot cells】,此人的 flow immunophenotyping 的結果如下圖,則下列何種細胞標記的結果正確? 】,此人最可能為下列何種疾病?
ACLL
BT-ALL
Cmultiple myeloma
Dplasma cell leukemia
詳細解析
本題觀念:
本題考核整合性臨床診斷能力,需綜合血液抹片形態學、CBC 數值、流式細胞術免疫表現型三項資料,確立最終診斷。正確診斷為慢性淋巴球性白血病(chronic lymphocytic leukemia, CLL)。
影像分析:
第一張圖(血液抹片):多個高倍鏡視野顯示大量小型成熟淋巴球(small mature lymphocytes),具有:
- 核染色質緻密深染(condensed/clumped chromatin)
- 核仁不明顯
- 細胞質稀少(scant cytoplasm)
- 視野 B 可見典型 smudge cells(籃狀細胞),此為 CLL 最具病理特徵性的抹片所見
- 未見 Reed-Sternberg cells(排除霍奇金淋巴瘤)
- 未見 Faggot cells(排除急性早幼粒細胞白血病,APL)
- 未見 prolymphocytes(排除 PLL)
第二張圖(Flow cytometry 散點圖):與前題相同,判讀結果確認:
- CD5(+)、CD19(+):B 細胞異常共同表現 T 細胞標記,CLL 的標誌性特徵
- CD23(+):CLL 高表現,MCL 陰性
- FMC7(-):CLL 典型陰性
- KAPPA(+)、LAMBDA(-)(V4 象限 99.2%
...(解析預覽)...

升級 VIP 解鎖圖文解析